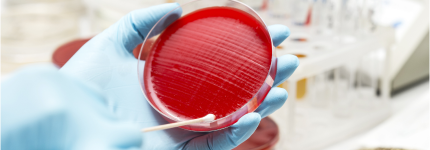
Bacterianas.png

Área de concentração: Doenças Infecciosas e Parasitárias
ALIMENTOS NA SAÚDE ÚNICA: IMPLICAÇÃO COM PATÓGENOS E RISCO AMBIENTAL
Estudo da relação alimento-saúde com ênfase em toxicologia, microbiologia e segurança de alimentos.
Profa. Dra. Jane Martha Graton Mikcha
Professora associada do Departamento de Análises Clínicas e Biomedicina (DAB/UEM) e docente permanente do PCS. Tem experiência na área Microbiologia de Alimentos, atuando principalmente nos seguintes temas: segurança de alimentos, qualidade microbiológica e controle de bactérias patogênicas de origem alimentar com ênfase em Salmonella.
Áreas de atuação: Microbiologia de alimentos; microrganismos associados às doenças transmitidas por alimentos.
44 3011 4813; jmgmikcha@uem.br; Currículo Lattes
Profa. Dra. Paula Aline Zanetti Campanerut-Sá
Professora adjunta do Departamento de Análises Clínicas e Biomedicina (DAB/UEM) e docente colaboradora do PCS. Atua nas seguintes linhas de pesquisa: Microbiologia de Alimentos e análise proteômica.
44 3011 4813; pazcsa@uem.br; Currículo Lattes.
Doenças bacterianas
Epidemiologia, diagnóstico e controle de doenças infecciosas bacterianas.
Profa. Dra. Regiane Bertin de Lima Scodro
Professora associada do Departamento de Análises Clínicas e Biomedicina (DAB/UEM) e docente permanente do PCS. Atuando principalmente nos seguintes temas: substâncias químicas naturais e sintéticas contra bactérias de interesse médico, como Mycobacterium tuberculosis e micobactérias não tuberculosas.
44 3011 5376; rblscodro@uem.br; regianebertin@gmail.com; Currículo Lattes.
Profa. Dra. Rosilene Fressatti Cardoso
Professora associada do Departamento de Análises Clínicas e Biomedicina (DAB/UEM) e docente permanente do PCS. Bolsista de Produtividade em Pesquisa do CNPq (Nível 2). Tem experiência na área de Análises Clínicas, com ênfase em Microbiologia Médica, atuando principalmente nos seguintes temas: diagnóstico laboratorial, cultura, detecção de resistência e epidemiologia da tuberculose, expressão gênica e estudos de novos compostos com ação em Mycobacterium tuberculosis e micobactérias não tuberculosas.
44 3011 5375; rfcardoso@uem.br; rfressatticardoso@gmail.com; Currículo Lattes.
Doenças virais
Epidemiologia, diagnóstico e controle de doenças infecciosas virais.
Professor associado do Departamento de Análises Clínicas e Biomedicina (DAB/UEM) e docente permanente do PCS. Tem experiência na área de Microbiologia, com ênfase em Microbiologia Médica. Atua principalmente nos seguintes temas: hepatite B, HIV/AIDS, hepatite C, arboviroses, prevalência, genotipagem, resistência ao tratamento.
Doenças por fungos
Estudo de mecanismos da interação fungo-hospedeiro e de fatores da biologia de fungos, epidemiologia, diagnóstico e controle de micoses humanas.
Profa. Dra. Terezinha Inez Estivalet Svidzinski
Professora associada aposentada do Departamento de Análises Clínicas e Biomedicina (DAB/UEM) e docente permanente do PCS. Bolsista de Produtividade em Pesquisa do CNPq (Nível 1D). Líder do grupo de pesquisa "Micologia humana e ambiental no processo saúde doença". Tem experiência na área de Farmácia e Análises Clínicas com ênfase em Micologia Médica. Atua principalmente nos temas relacionados a: fatores de virulência de fungos patogênicos, leveduras envolvidas em infecções hospitalares, paracoccidioidomicose, candidíase vulvovaginal, diagnóstico e epidemiologia de micoses humanas e fitoterápicos com propriedades antifúngicas.
44 3011 4809; 44 3011 5444; terezinha.svidzinski@gmail.com; Currículo Lattes.
Profa. Dra. Melyssa Fernanda Norman Negri
Professora adjunta do Departamento de Análises Clínicas e Biomedicina (DAB/UEM) e docente permanente do PCS. Membro da Comissão Interna de Biossegurança (CIB/UEM). Líder de grupo de Pesquisa em Tecnologias CNPq - Micobioma: inter-relações, benefícios, prejuízos, prevenção e controle no contexto one health (OneMyco). Tem experiência na área de Microbiologia, com ênfase em Micologia Médica. Atua principalmente nos seguintes temas: biofilmes microbianos, infecção hospitalar, infecções fúngicas, interação fungo-hospedeiro, cultura celular e modelos alternativos.
44 3011 4809; mnegri@uem.br; Currículo Lattes.
Doenças parasitárias
Epidemiologia, controle e tratamento de zoonoses e parasitoses de interesse em saúde pública.
Profª. Drª. Daniele Stefanie Sara Lopes Lera Nonose
Professora Adjunta do Departamento de Análises Clínicas e Biomedicina (DAB/UEM). Tem experiência na área de Imunologia, atuando principalmente nos seguintes temas: leishmaniose tegumentar americana, diagnóstico laboratorial, prognóstico, ação terapêutica e terapia fotodinâmica. Possui expertise em epidemiologia e revisão sistemática, com foco no desenvolvimento de métodos diagnósticos e compreensão da resposta imune em doenças parasitárias e infecciosas. Áreas de atuação: Imunologia Clínica; Diagnóstico Laboratorial de Leishmanioses; e Epidemiologia de Doenças Infecciosas.
44 3011 1376; dssllnonose@uem.br; Currículo Lattes
Prof. Dr. Max Jean de Ornelas Toledo
Professor associado do Departamento de Ciências Básicas da Saúde (DBS/UEM) e docente permanente do PCS. Bolsista de Produtividade em Pesquisa do CNPq (Nível 2). Coordenador do Programa de Pós-Graduação em Ciências Biológicas - Biologia Celular e Molecular (PBC/UEM), Coordenador da Central de Tecnologia em Saúde COMCAP/UEM. Tem experiência na área de Parasitologia e Biologia Molecular, com ênfase em Protozoologia de Parasitos. Atua principalmente nos seguintes temas: Trypanosoma cruzi, genotipagem, quimioterapia experimental, doença de Chagas oral, camundongos, reservatórios mamíferos silvestres, predição espacial de áreas de risco, enteroparasitos em populações indígenas, Estado do Paraná e Amazônia.
44 3011 8991; 44 3011 8985; 44 3011 4833; mjotoledo@uem.br; Currículo Lattes.
Profa. Dra. Priscilla de Laet Sant´Ana
Professora adjunta do Departamento de Ciências Básicas da Saúde (DBS/UEM) e docente colaboradora do PCS. Tem experiência na área de Patologia e Doenças Infecciosas e Parasitárias, com ênfase em Doenças Parasitárias, atuando principalmente nos seguintes temas: Toxoplasmose – reposição de fármacos e compostos naturais para pesquisa de novas opções de tratamento in vivo (modelo animal); patologia e mecanismos patogênicos; toxoplasmose gestacional e congênita – diagnóstico, epidemiologia e controle.
44 3011-5931; plsantana@uem.br; Curriculo Lattes